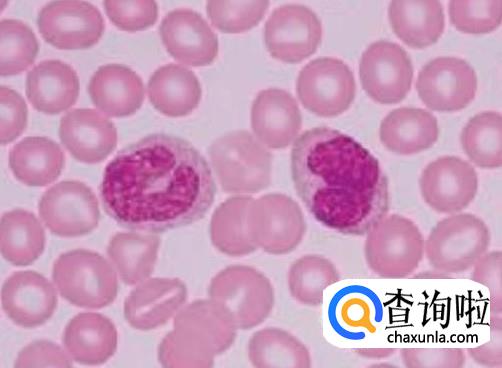

人体各大器官细胞更换所需时间
知识问答小编
0次浏览
2022-10-24 10:26:11
最佳经验
本文由作者推荐
详细内容
- 01
知道骨骼更新一次的时间是多久吗?骨骼一般更新的时间是10年。

- 02
肺表层的细胞更新一次的时间是2-3周。肺细胞是在不断更新,肺部深处气囊细胞更新叫稳定,大约一年

- 03
人体中胃的更新时间是在7天一次。胃黏膜上皮细胞处于脱落与生长的情况下,胃黏膜表面每三天更新一次
- 04
皮肤细胞是28天左右一次,上皮细胞在皮肤细胞中最活跃,处于不断更新状况,会快速更新。










